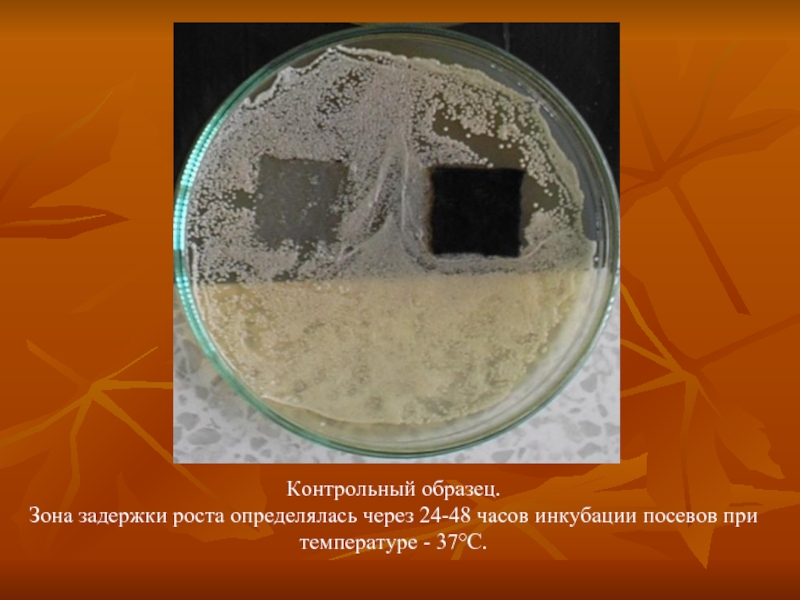

- Главная
- Разное
- Дизайн
- Бизнес и предпринимательство
- Аналитика
- Образование
- Развлечения
- Красота и здоровье
- Финансы
- Государство
- Путешествия
- Спорт
- Недвижимость
- Армия
- Графика
- Культурология
- Еда и кулинария
- Лингвистика
- Английский язык
- Астрономия
- Алгебра
- Биология
- География
- Детские презентации
- Информатика
- История
- Литература
- Маркетинг
- Математика
- Медицина
- Менеджмент
- Музыка
- МХК
- Немецкий язык
- ОБЖ
- Обществознание
- Окружающий мир
- Педагогика
- Русский язык
- Технология
- Физика
- Философия
- Химия
- Шаблоны, картинки для презентаций
- Экология
- Экономика
- Юриспруденция
ЦЕЛЬ РАБОТЫ презентация
Содержание
- 1. ЦЕЛЬ РАБОТЫ
- 2. С технико-экономической точки зрения перспективность разработки технологических
- 3. Примеры подобной продукции, производимой импортными компаниями
- 5. Распределение по размерам наночастиц серебра, в составе
- 6. Изображение наночастиц серебра в модифицирующем растворе
- 7. Изображение наночастиц серебра в азотнокислых экстрактах образцов продукции.
- 8. Лазерно-искровой экспресс-анализатор элементного состава объектов природной
- 9. По результатам количественного химического анализа содержание наночастиц
- 10. Результаты определения наночастиц серебра в образцах методом масс-спектрометрии
- 11. Контрольный образец. Зона задержки роста определялась
- 12. Результат воздействия исследуемых образцов текстильных изделий на рост бактерий Staphуlococcus aureus.
- 13. Внешний вид образцов трикотажного полотна после испытаний действия боицида.
- 14. Продукция фирмы «Эдедьхаус»
- 15. Возможности применения технологии модифицирования трикотажных и текстильных
- 16. Организации исполнители проекта ЗАО NT MDT ЗАО
Слайд 1ЦЕЛЬ РАБОТЫ
Промышленное внедрение технологий обработки натуральных материалов и изделий из них
Технологические процессы обработки должны обеспечить нанесение и надежную фиксацию наноразмерных частиц металлов на поверхности натуральных материалов и изделий из них.
Слайд 2С технико-экономической точки зрения перспективность разработки технологических процессов нанесения наноразмерных частиц
реализуется на стандартном оборудовании,
интегрируется в существующие технологии обработки (отделки) натуральных материалов и изделий из них,
обеспечивается возможность получения натуральных материалов с различной концентрацией и плотностью покрытия,
процесс идет на воздухе, что значительно удешевляет технологию (не требуется вакуум или атмосфера инертного газа, чтобы не допустить химических превращений и нет необходимости использования дорогостоящего оборудования, проведения дополнительных операций и др.).
Слайд 5Распределение по размерам наночастиц серебра, в составе раствора, применяемого для наномодификации
Слайд 8Лазерно-искровой экспресс-анализатор
элементного состава объектов природной среды
Автоматизированный лазерно-искровой экспресс-анализатор создан в
Слайд 9По результатам количественного химического анализа содержание наночастиц серебра в четырех исследованных
Слайд 11Контрольный образец.
Зона задержки роста определялась через 24-48 часов инкубации посевов
Слайд 12Результат воздействия исследуемых образцов текстильных изделий на рост бактерий Staphуlococcus aureus.
Слайд 15Возможности применения технологии модифицирования трикотажных и текстильных изделий наноразмерными частицами металлов
Товары народного потребления
Спецодежда
Форменная одежда
Товары медицинского назначения
Травматология и ортопедия
Спорт и спортивная медицина
Слайд 16Организации исполнители проекта
ЗАО NT MDT
ЗАО ЦНТБ
НПО «ТАЙФУН»
ЦНИИШП
МГУДТ
МГТУ им. А.Н.Косыгина
ООО «МЭР»
ООО «ЭДЕЛЬХАУС»
ООО
ЗАО «Инкар-м»